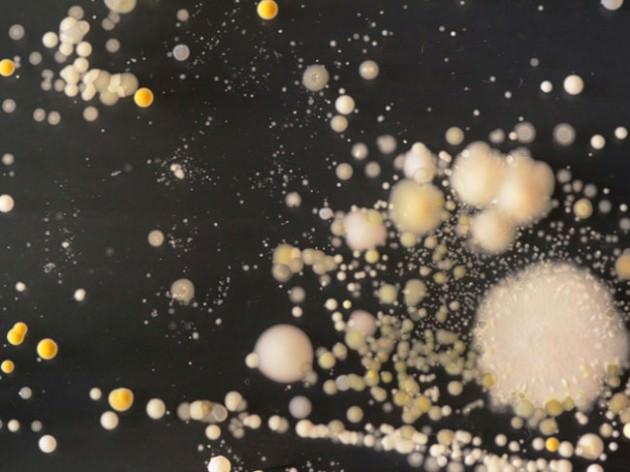
Üniversitede süren çalışmalar sırasında bakteriler fotograflandı ve bu görüntüler büyütüldü.

Cep telefonunda yaşayan canlılar
27.02.2013
15:15
Üniversitede süren çalışmalar sırasında bakteriler fotograflandı ve bu görüntüler büyütüldü.